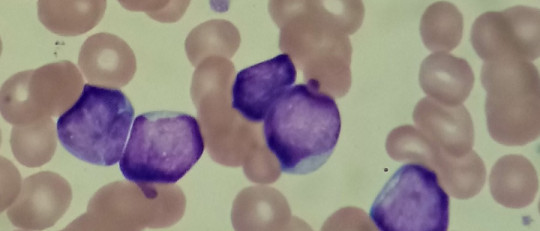
Linfoblastos

Dentro del condicionamiento operante, el contraste conductual es un fenómeno en el que se consigue incrementar o reducir la conducta de un sujeto tras haber introducido un cambio en esquema operante que se le había enseñado en ensayos previos.
Este fenómeno puede ser útil en diferentes contextos, en especial el educativo y en investigación conductual, aspectos que veremos más a fondo a continuación.
- Artículo relacionado: "Conductismo: historia, conceptos y autores principales"
Contraste conductual: ¿qué es?
El contraste conductual, también llamado efecto de contraste negativo y efecto de contraste positivo, es el cambio en tasa de respuesta o latencia de respuesta tras modificarse uno de los componentes en un entrenamiento de discriminación operante múltiple de refuerzo. Puede definirse también como el fenómeno que se da cuando se introduce un cambio en la magnitud o frecuencia de un reforzador que hace que se modifiquen parámetros relacionados con la ejecución de una conducta, como su latencia, frecuencia, precisión e intensidad.
El fenómeno del contraste conductual es común dentro del condicionamiento operante, en especial en tareas de discriminación con dos o más respuestas. Cuando la magnitud del reforzador es incrementada (p. ej., se da más comida) o su frecuencia aumenta (p. ej., se da comida más veces), en principio, la ejecución de la conducta mejora, aumenta y/o es más intensa. En cambio, si se reduce la magnitud o su frecuencia es menor, es esperable que la conducta del sujeto empeore, realice menos ejecuciones o sea menos intensa.
Ejemplo
Por ejemplo, supongamos que tenemos una paloma dentro de una cámara de condicionamiento operante y que para recibir la recompensa (comida) debe pulsar uno de los dos botones, uno verde y otro rojo. Al principio del entrenamiento da igual cual sea el color del botón, la paloma recibirá la comida siempre y cuando pulse uno de los dos, esto es, el color no está asociado con el premio, sino el hecho de pulsar uno de los dos botones.
Sin embargo, ya avanzado el experimento y viendo que el animal ha asociado pulsar un botón con la comida, se introduce un cambio. Ahora, al clicar el botón verde, la paloma recibe comida con menos frecuencia que antes, mientras que el botón rojo sigue aportando tanta comida como antes. Ante este cambio podrían darse dos situaciones.
Por un lado podría pasar que la paloma, viendo que el botón trae consigo comida pero con menos frecuencia, empiece a pulsarlo más veces. Si antes con un picotazo le bastaba para recibir el premio, ahora necesita cinco para obtener el mismo resultado, algo que la obliga a clicar el botón verde más veces de lo que antes hacía y, por lo tanto, hay un incremento en la tasa de emisión de la misma conducta.
Sin embargo, y por el otro lado, es bastante probable que la paloma reduzca su tasa de picotazos ante el botón verde y lo incremente en el botón rojo, puesto que es el que le sigue dando alimento de forma constante. En este caso tendríamos un efecto de contraste negativo, puesto que la paloma ha reducido su conducta con el botón verde debido a que este ha dejado de recompensarla tan a menudo, mientras que picotea el otro botón con mayor frecuencia a pesar de que sigue dando la misma cantidad de alimento que antes.
- Quizás te interese: "Condicionamiento operante: conceptos y técnicas principales"
Historia del concepto
En 1942, Leo P. Crespi midió cómo de rápido corrían las ratas en un circuito en forma de callejón en el que al final se encontraban diferentes cantidades de comida. Había ratas que recibían mucha comida, mientras que otras recibían poca. El investigador observó que la cantidad de comida encontrada al final del circuito parecía influir en la velocidad, puesto que a mayor recompensa, más rápido parecía que corrían los roedores.
Viendo esta supuesta correlación el investigador optó por introducir un cambio. Cogió algunas ratas que habían sido entrenadas en los circuitos con mucha comida al final del callejón y las trasladó a circuitos en donde se encontraba menos comida. Hizo lo mismo con algunas ratas que habían sido entrenadas en circuitos con poca comida, trasladándolas ahora a circuitos con mayor recompensa.
Crespi vio que las ratas que originalmente habían sido entrenadas con la mayor cantidad de comida, cuando se encontraban en un circuito con poca recompensa iban más lentas, incluso más que las ratas que hacían de control en el mismo tipo de circuito con poca comida y que no habían sido trasladadas a ningún sitio. Algo similar pasaba con las ratas trasladadas de circuitos con poca recompensa a con más recompensa, que ahora corrían muy rápido, más incluso que los sujetos control.
Con sus experimentos de 1942 Crespi acababa de toparse con el efecto contraste negativo y el efecto contraste positivo, respectivamente. Originalmente este investigador no llamó al efecto de contraste conductual así, sino que prefirió hablar de depresión y elación conductuales. Sin embargo, en 1949 David Zeaman sugirió que se usara una nueva nomenclatura para estos efectos, siendo a él a quien se le atribuye los nombres de contraste conductual negativo y contraste conductual positivo.

Contraste negativo y contraste positivo y utilidad educativa
El efecto de contraste negativo se muestra como algo evidente dentro del condicionamiento operante cuando se intenta reforzar una conducta particular por medio de la recompensa y, después, la recompensa es eliminada o reducida. Esto produce una situación en la que el sujeto, quien antes había sido recompensado por emitir una conducta X, ahora no recibe tal premio, lo cual no lo motiva tanto para emitir ese mismo comportamiento.
Se ha sugerido que detrás del fenómeno del contraste negativo lo que realmente sucede es que, tras haber recompensado un comportamiento en el sujeto, sea animal o persona, este lo llega a entender como una especie de “trabajo”. De la misma manera que en el puesto de empleo no pretendemos trabajar sin recibir algo a cambio, tras haber hecho que el sujeto experimental asocie un estímulo con realizar una conducta y recibir un premio, si se suprime tal premio dejará de hacer la conducta porque ya no le beneficia.
Este fenómeno puede sernos útil en la vida diaria, especialmente en el ámbito educativo. Si bien dar premios a los niños para motivarlos es una buena estrategia, darles premios cada vez que, por ejemplo, leen un libro puede ser contraproducente. Al principio leerán muchos libros, motivados por recibir su recompensa (p. ej., su comida favorita). Si decidimos suprimir el premio, confiados en que el niño ha adquirido el hábito de leer, corremos el riesgo de que deje de hacerlo, puesto que puede pasar que lo haya hecho todo este tiempo para conseguir el premio y si ahora no lo consigue no ve la necesidad de seguir leyendo.
Por otro lado, podemos beneficiarnos del efecto de contraste positivo en el ámbito educativo. Como comentábamos este efecto se da cuando el premio es incrementado o mayor su frecuencia de aparición, haciendo que el sujeto haga más veces o con mayor intensidad la conducta reforzada. De aplicarse esta estrategia adecuadamente, se puede conseguir que el sujeto a quien se le aplica se sienta motivado para emitir más veces una conducta que nos resulta deseable.
Relacionándolo con el caso anterior, podemos crear una situación de contraste conductual positivo haciendo que, si el niño nos da muestras de que ha incrementado el nivel de dificultad en su lectura, en vez de darle su comida favorita una vez, se la demos dos veces. Si bien lo deseable es que adquiera el hábito de leer por sí solo, esta claro que esta estrategia incrementará la cantidad de libros leídos, haciendo que sea más hábil en la lectura.
Sea cual sea el fin con el que se quiere aplicar el contraste conductual, lo cierto es que bien usado es un fenómeno que puede sernos beneficioso para iniciar el cambio de conducta en alguien. Su aplicación tanto en contexto de laboratorio como en ámbito educativo es algo que desde luego puede ser muy útil tanto para erradicar una determinada conducta como fomentar cualquiera que nos plazca.


Newsletter PyM
La pasión por la psicología también en tu email
Únete y recibe artículos y contenidos exclusivos
Suscribiéndote aceptas la política de privacidad